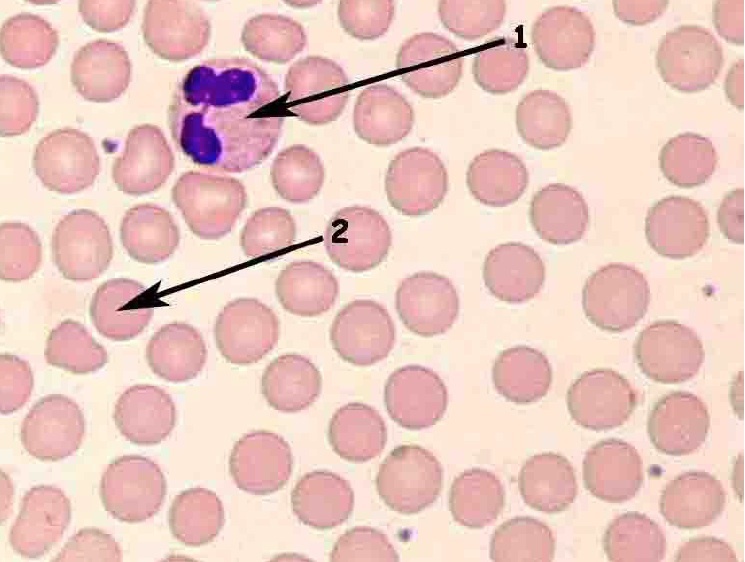

Tissues
Groups of cells that are similar in structure and function
Four primary tissue types
Epithelium, connective tissue, nervous tissue, and muscle
Epithelial tissue (epithelium)
A sheet of cells that covers a body surface or lines a body cavity
Function of epithelial tissue
Protection, absorption, filtration, excretion, secretion, and sensory reception

Adipose Tissue
Blood

Cardiac muscle

Adipose tissue

Bone (osseous tissue)

Cardiac muscle

Hyaline cartilage

Nervous tissue

Simple columnar epithelium

Simple Squamous Epithelium

Smooth Muscle Tissue

Transitional Epithelium

Smooth Muscle Tissue

Transitional epithelium

Skeletal muscle tissue

Simple cuboidal epithelium

Pseudostratified Ciliated Columnar Epithelium

Hyaline Cartilage

Areolar connective tissue

Bone (osseous tissue)